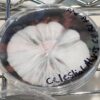

Celestial Abyss is by far one of my favorite Yeti isolations. Original iso was made by Garlic Johnson. I’ve worked 3 generations while continuing isolations throughout that timeframe.
Typically produces medium to large size fruits, caps have some krinkle to them with some dark blue tones as maturity peaks.

Reviews
There are no reviews yet.